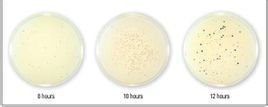
感受態細胞

製作方法
CaCl2法
1.將快速生長的大腸桿菌置於經低溫(0℃)預處理的低滲氯化鈣溶液中,便會造成細胞膨脹,同時Ca2+會使 細胞膜 磷脂雙分子層形成液晶結構,促使細胞外膜與內膜間隙中的部分核酸酶解離開來,離開所在區域,誘導細胞成為感受態細胞
感受態細胞
感受態細胞細胞膜 通透性發生變化,極易與外源DNA相粘附並在 細胞表面形成抗 脫氧核糖核酸酶的羥基-磷酸鈣複合物。
聯合其它的二價金屬離子(如Mn、Co)、DMSO或還原劑等物質處理細菌,則可使轉化率提高100~1000倍。
2.此時,將該體系轉移到42℃下做短暫的熱刺激(90s), 細胞膜的液晶結構會發生劇烈擾動,並隨機出現許多間隙,外源DNA就可能被細胞吸收。進入細胞的外源DNA分子通過複製、表達,實現 遺傳信息的轉移,使受體細胞出現新的遺傳性狀。
3.將轉化後的細胞在 選擇性培養基上培養,篩選出帶有外源DNA分子的 陽性克隆。
電轉法
電擊法不需要預先誘導細菌的感受態,依靠短暫的電擊,促使DNA進入細菌,轉化率最高能達到109~1010轉化子/ug閉環DNA。因操作簡便,愈來愈為人們所接受
意義
將構建好的載體轉入感受態細胞進行表達,不僅可以檢驗重組載體是否構建成功,最主要的是感受態細胞作為重組載體的宿主可以進行後續實驗,如蛋白質表達純化等工作。
分子生物學實驗技術
| 分子生物學(molecularbiology) 是從分子水平研究作為生命活動主要物質基礎的生物大分子結構與功能,從而闡明生命現象本質的科學。而分子生物學的各種實驗方法,是本學科得以高速發展和不斷取得突破性成就的基礎。隨著學科的發展和各相關交叉學科的進步,分子生物學實驗技術必定會越來越高效與精準,成為人類探索自然、改善自然的有力工具。 |
